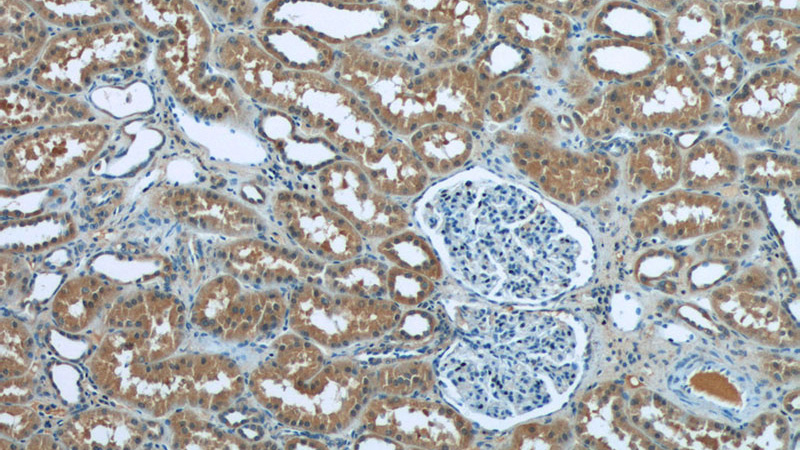
Immunohistochemistry of paraffin-embedded human kidney tissue slide using Catalog No:114803(RPGR Antibody) at dilution of 1:50 (under 10x lens)
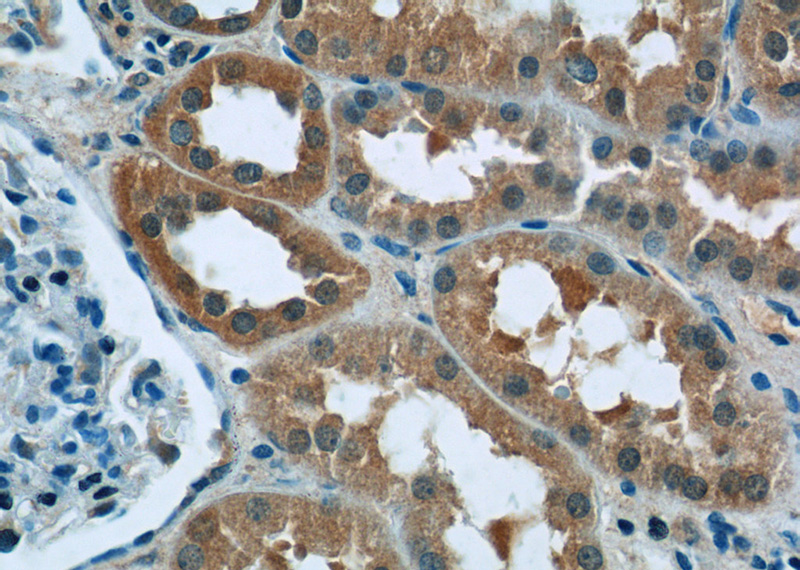
Immunohistochemistry of paraffin-embedded human kidney tissue slide using Catalog No:114803(RPGR Antibody) at dilution of 1:50 (under 40x lens)

-
Product Name
RPGR antibody
- Documents
-
Description
RPGR Rabbit Polyclonal antibody. Positive WB detected in mouse eye tissue, mouse liver tissue, SH-SY5Y cells, Y79 cells. Positive IF detected in hTERT-RPE1 cells. Positive IHC detected in human kidney tissue, human heart tissue. Observed molecular weight by Western-blot: 100-105 kDa, 70 kDa
-
Tested applications
ELISA, WB, IF, IHC
-
Species reactivity
Human, Mouse; other species not tested.
-
Alternative names
COD1 antibody; CORDX1 antibody; CRD antibody; orf15 antibody; PCDX antibody; RP15 antibody; RP3 antibody; RPGR antibody; XLRP3 antibody
-
Isotype
Rabbit IgG
-
Preparation
This antibody was obtained by immunization of RPGR recombinant protein (Accession Number: BC031624). Purification method: Antigen affinity purified.
-
Clonality
Polyclonal
-
Formulation
PBS with 0.02% sodium azide and 50% glycerol pH 7.3.
-
Storage instructions
Store at -20℃. DO NOT ALIQUOT
-
Applications
Recommended Dilution:
WB: 1:200-1:2000
IHC: 1:20-1:200
IF: 1:10-1:100
-
Validations

mouse eye tissue were subjected to SDS PAGE followed by western blot with Catalog No:114803(RPGR antibody) at dilution of 1:500

IF result of anti-RPGR(Catalog No:114803) in hTERT-RPE1 cell by Dr. Seongjin Seo.
Immunohistochemistry of paraffin-embedded human kidney tissue slide using Catalog No:114803(RPGR Antibody) at dilution of 1:50 (under 10x lens)
Immunohistochemistry of paraffin-embedded human kidney tissue slide using Catalog No:114803(RPGR Antibody) at dilution of 1:50 (under 40x lens)
-
Background
RPGR is a protein with a series of six RCC1-like domains (RLDs), characteristic of the highly conserved guanine nucleotide exchange factors. The encoded protein is found in the Golgi body and interacts with RPGRIP1. This protein localizes to the outer segment of rod photoreceptors and is essential for their viability. Mutations in this gene have been associated with X-linked retinitis pigmentosa (XLRP). Multiple alternatively spliced transcript variants that encode different isoforms of this gene have been reported, but the full-length natures of only some have been determined. This antibody can recgnize all the isofoms of RPGR.
Related Products / Services
Please note: All products are "FOR RESEARCH USE ONLY AND ARE NOT INTENDED FOR DIAGNOSTIC OR THERAPEUTIC USE"
